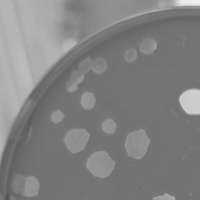

Microbacterium phage Forester
Add or modify phage thumbnail images to appear at the top of this page.
Know something about this phage that we don't? Modify its data.
| Detailed Information for Phage Forester | |
| Discovery Information | |
| Isolation Host | Microbacterium foliorum NRRL B-24224 |
| Found By | Joe Capewell |
| Year Found | 2025 |
| Location Found | St Andrews, Scotland |
| Finding Institution | University of St Andrews |
| Program | Unavailable |
| From enriched soil sample? | Yes |
| Isolation Temperature | 30°C |
| GPS Coordinates | Unavailable |
| Discovery Notes | The sample from which this phage was isolated was collected from a plant pot in the St Andrews Biomedical Sciences Research Complex. The plant was a Flamingo Flower, sold by Morrisons. The sample was collected from the surface, with an approximate air temperature of 19 °C, soil was fibrous potting soil. |
| Naming Notes | This phage was given a name my dad suggested for me when I was born. |
| Sequencing Information | |
| Sequencing Complete? | No |
| Genome length (bp) | Unknown |
| Character of genome ends | Unknown |
| Fasta file available? | No |
| Characterization | |
| Cluster | Unclustered |
| Subcluster | -- |
| Annotating Institution | Unknown or unassigned |
| Annotation Status | Not sequenced |
| Plaque Notes | Plaques are regularly circular, and of a medium size with little variation. Plaques are completely clear, with no halo. |
| Has been Phamerated? | No |
| Publication Info | |
| Uploaded to GenBank? | No |
| GenBank Accession | None yet |
| Refseq Number | None yet |
| Archiving Info | |
| Archiving status | Not in Pitt Archives |
| Available Files | |
| Plaque Picture | Download |